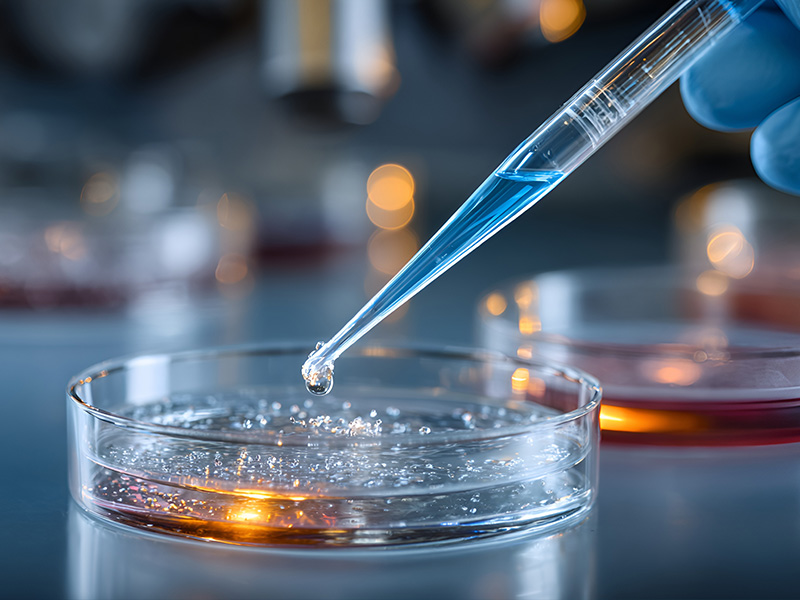

细胞凋亡过程中,促凋亡蛋白会引起线粒体外膜通透(MOMP),导致细胞色素C释放以及随后的caspase-9和凋亡级联反映的激活。而MOMP通常与线粒体内膜电位(mitochondrialmembranepotential,ΔΨm)去极化相关。

线粒体膜电位是指由线粒体内膜两侧质子分布不均一而形成的电化学梯度。线粒体膜电位的下降被认为是细胞早期凋亡的一个标志性事件。
JC-1(也称CBIC2或5,5′,6,6′-Tetrachloro-1,1′,3,3′-tetraethyl-imidacarbocyanine)是一种广泛用于检测线粒体膜电位的可渗透膜的亲脂性阳离子染料,能够选择性地进入线粒体基质,其荧光特性会随着线粒体膜电位(ΔΨm)的变化而改变。
正常生理状态下,线粒体负电性高时,JC-1可以在线粒体的基质中聚集,形成多聚体,红色荧光强;细胞凋亡时,线粒体去极化产生,负电性低,JC-1不能聚集在线粒体的基质中,此时JC-1以单体形式存在,绿色荧光强。因此,JC-1荧光颜色的转变可用来指示线粒体膜电位的变化情况。
JC-1单体的最大激发波长为514nm,最大发射波长为527nm,可用FITC通道进行检测;JC-1的最大激发波长为585nm,最大发射波长为590nm,可用PE通道进行检测。

流式数据解读
JC-1检测法常用红绿荧光的相对比例来衡量线粒体去极化的比例。图中双阳细胞群为活细胞,FITC+PE-细胞群为凋亡细胞。